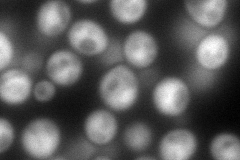
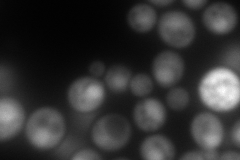
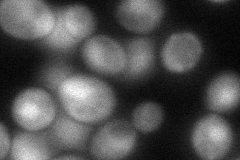
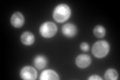

View description
Glyceraldehyde-3-phosphate dehydrogenase, isozyme 2, involved in glycolysis and gluconeogenesis; tetramer that catalyzes the reaction of glyceraldehyde-3-phosphate to 1,3 bis-phosphoglycerate; detected in the cytoplasm and cell wall
Localization:
Intensity:
Fold change:
Significance:
-
C’ GFP library in SD

cytosol1973.61 -
N' NOP1pr-GFP in SD
cytosol,nucleus270.301 -
N' TEF2pr-mCherry in SD
cytosol,nucleus325.747 -
N' NATIVEpr-GFP in SD

cytosol,nucleus611.257 -
N' TEF2pr-VC and Cyto-VN in SD
cytosol,nucleus84.9421 -
C’ GFP library in SD+DTT

cytosol3261.821.65Yes -
C’ GFP library in SD+H2O2

cytosol2806.681.42Yes -
C’ GFP library in Starvation Media
nucleusN/AN/AYes -
C’ GFP library on the background of Pup2-DaMP

cytosol -
C’ GFP library on the background of CCT mutant

cytosol2113.271.07076No
